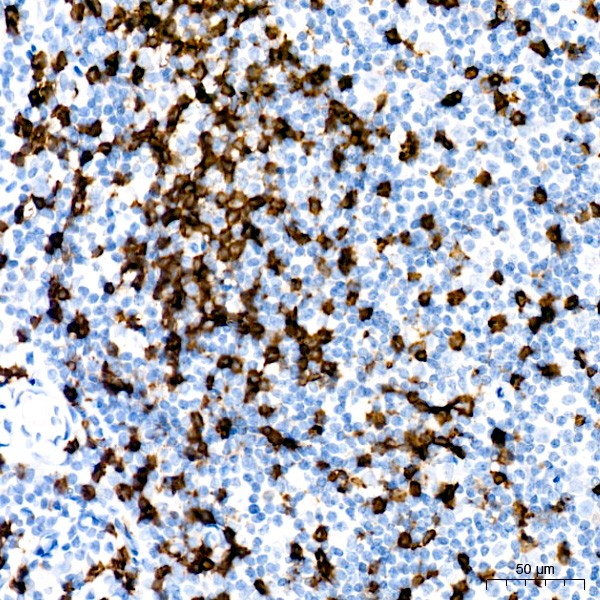
A22219: CD8A Rabbit mAb

CD8A Rabbit mAb (A22219)
$148.00 – $548.00
Abclonal CD8A Rabbit mAb (Catalog Number: A22219) is a cell surface glycoprotein found on most cytotoxic T lymphocytes that mediates efficient cell-cell interactions within the immune system.
- Details & Specifications
- References
| Catalog No. | A22219 |
|---|---|
| Product Name | CD8A Rabbit mAb (A22219) |
| Supplier Name | ABclonal, Inc. |
| Brand Name | Abclonal |
| Synonyms | CD8; p32; Leu2; CD8alpha |
| Gene Name | CD8A |
| Protein Name | CD8A |
| Uniprot/Swissprot ID | P01732 |
| Gene ID | 925 |
| Clone | ARC55249 |
| Clonality | Monoclonal |
| Source/Host | Rabbit |
| Reactivity | Human |
| Conjugate | Unconjugated |
| Note | Products will be shipped from the warehouse in Massachusetts. Promotion is running from time to time. Welcome to send a request for quote to message@sydlabs.com. |
| Order Offline | Syd Labs, Inc. 4 Avenue E, Hopkinton, MA 01748 USA. Phone: 1-617-401-8149 Fax: 1-617-606-5019 Email: message@sydlabs.com |
Description
A22219: CD8A Rabbit mAb
The CD8 antigen is a cell surface glycoprotein found on most cytotoxic T lymphocytes that mediates efficient cell-cell interactions within the immune system. The CD8 antigen acts as a coreceptor with the T-cell receptor on the T lymphocyte to recognize antigens displayed by an antigen presenting cell in the context of class I MHC molecules. The coreceptor functions as either a homodimer composed of two alpha chains or as a heterodimer composed of one alpha and one beta chain. Both alpha and beta chains share significant homology to immunoglobulin variable light chains. This gene encodes the CD8 alpha chain. Multiple transcript variants encoding different isoforms have been found for this gene. The major protein isoforms of this gene differ by the presence or absence of a transmembrane domain and thus differ in being a membrane-anchored or secreted protein.
Immunogen Information about CD8A Rabbit mAb (A22219)
Immunogen:Recombinant fusion protein containing a sequence corresponding to amino acids 22-182 of human CD8A (NP_001759.3).
Sequence:SQFRVSPLDRTWNLGETVELKCQVLLSNPTSGCSWLFQPRGAAASPTFLLYLSQNKPKAAEGLDTQRFSGKRLGDTFVLTLSDFRRENEGYYFCSALSNSIMYFSHFVPVFLPAKPTTTPAPRPPTPAPTIASQPLSLRPEACRPAAGGAVHTRGLDFACD
Gene ID:925
Swiss prot:P01732
Synonyms:CD8; p32; Leu2; CD8alpha; CD8A
Calculated MW:21kDa/25kDa/30kDa
Observed MW:Refer to figures
Images of CD8A Rabbit mAb (A22219)

Immunohistochemistry analysis of paraffin-embedded human appendix using CD8A Rabbit mAb (A22219) at dilution of 1:100 (40x lens).Perform high pressure antigen retrieval with 10 mM citrate buffer pH 6.0 before commencing with IHC staining protocol.

Immunohistochemistry analysis of paraffin-embedded human tonsil using CD8A Rabbit mAb (A22219) at dilution of 1:100 (40x lens).Perform high pressure antigen retrieval with 10 mM citrate buffer pH 6.0 before commencing with IHC staining protocol.
Please remember our product information: CD8A Rabbit mAb (Catalog Number: A22219) Abclonal